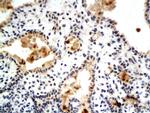
Phospho-Estrogen Receptor alpha (Ser104, Ser106) Antibody in Immunohistochemistry (Paraffin) (IHC (P))

Search
Bioss
Phospho-Estrogen Receptor alpha (Ser104, Ser106) Polyclonal Antibody
{{$productOrderCtrl.translations['antibody.pdp.commerceCard.promotion.promotions']}}
{{$productOrderCtrl.translations['antibody.pdp.commerceCard.promotion.viewpromo']}}
{{$productOrderCtrl.translations['antibody.pdp.commerceCard.promotion.promocode']}}: {{promo.promoCode}} {{promo.promoTitle}} {{promo.promoDescription}}. {{$productOrderCtrl.translations['antibody.pdp.commerceCard.promotion.learnmore']}}
图: 1 / 1
Phospho-Estrogen Receptor alpha (Ser104, Ser106) Antibody (BS-3131R) in IHC (P)
产品信息
BS-3131R
种属反应
宿主/亚型
分类
类型
抗原
偶联物
形式
浓度
规格
纯化类型
保存液
内含物
保存条件
运输条件
靶标信息
Estrogen Receptors (ER) are members of the steroid/thyroid hormone receptor superfamily of nuclear receptors. The estrogen receptor is a ligand-activated transcription factor, that when bound to estrogen hormone, induces a conformational change that allows dimerization and binding to estrogen response elements (ERE) in DNA. When bound to EREs, ER can positively or negatively regulate gene transcription through the recruitment of coactivator or corepressor proteins. There are two different forms of the estrogen receptor, alpha and beta, encoded by separate genes (ESR1 and ESR2, respectively). Due to alternative RNA splicing, at least 4 estrogen receptor-alpha isoforms are known to exist (Isoform 1 (66 kDa), Isoform 2 (53 kDa), Isoform 3 (47 kDa), Isoform 4 (35 kDa)). Estrogen receptors are widely expressed in different tissue types and are essential for sexual development and reproductive function. They also play a role in other tissues such as bone. Estrogen receptors are involved in pathological processes including breast cancer, endometrial cancer, and osteoporosis.
仅用于科研。不用于诊断过程。未经明确授权不得转售。
篇参考文献 (0)
生物信息学
蛋白别名: DKFZp686N23123; E2 receptor alpha; ER; Er alpha; ER delta E7 isoform; ER-alpha; ER-alpha; del.3*,+1*,4,5,6,7* variant; ER-alpha; del.3*,4,5,6,7*/770 variant; ER-alpha; del.3*,4,5,6,7,8*/862 variant; ER-alpha; del.4*,5*,7 variant; ER-alpha; del.4*,5,6*/548 variant; ER-alpha; del.4*,5,6,7*/714 variant; ER-alpha; del.4*,5,6,7,8*/754 variant; ER-alpha; estrogen receptor alpha delta 3*,4,5,6,7*/819 cingulate gyrus isoform; ER-alpha; estrogen receptor alpha delta 3*,4,5,6,7*/833 superior frontal gyrus isoform; ER-alpha; estrogen receptor alpha delta 4*,5,6,7*/747 substantia nigra isoform; ER36; esr 1; esr-1; Estradiol receptor; estrogen nuclear receptor alpha; Estrogen receptor; estrogen receptor 1 (alpha); estrogen receptor alpha c-terminus splice variant 1-2; estrogen receptor alpha E1-E2-1-2; estrogen receptor alpha E1-N2-E2-1-2; estrogen receptor alpha variant delta 4; estrogen receptor protein; estrogen receptor-related protein; hER-alpha36; lacks a part of the exon 3, exons 4-6, and part of exon 7; contains an 822 base in frame deletion; lacks most of the exon 3, exons 4-7, and part of exon 8; lacks most of the exon 4, exons 5-6, and part of exon 7; lacks the end of the exon 3, exons 4-7, and part of exon 8; MB1; Nuclear receptor subfamily 3 group A member 1; oestrogen receptor alpha; receptor; RP1-130E4.1; steroid hormone receptor; unnamed protein product
基因别名: ER; ER-alpha; ERa; ERalpha; ESR; ESR1; ESRA; Estr; Estra; ESTRR; NR3A1; RNESTROR
UniProt ID: (Human) P03372, (Mouse) P19785, (Rat) P06211
Entrez Gene ID: (Human) 2099, (Mouse) 13982, (Rat) 24890




